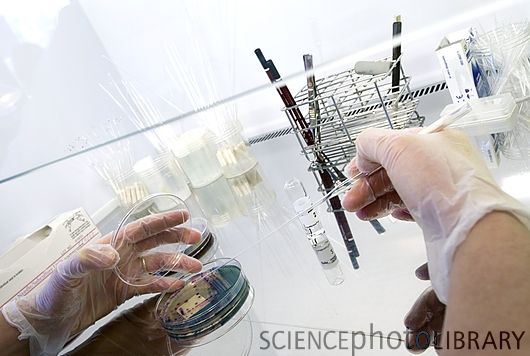

“超级病菌”具有极强的抗药性(图)
抗生素作为药物问世还不到一百年,如今具有抗药性的“超级病菌”已让医学界头疼。细菌的抗药性如何产生?加拿大研究人员最近报告说,他们从3万多年前的细菌DNA中分离出了抗药基因,首次通过严谨的实验表明,抗药性基因根植于细菌,甚至远早于人类发现抗生素。
加拿大麦克马斯特大学的研究人员从该国西北部的育空地区钻取沉积物,取得了冰封3万多年的土壤样本,从中提取出细菌DNA。他们采用严格方法保证样本不被现代微生物所污染,确认这些DNA属于古代细菌。
分析显示,这些DNA里有多种抗药基因碎片,例如针对青霉素、四环素和万古霉素的基因。研究人员以这些古代DNA碎片为基础,复原出一个抗万古霉素的基因以及它所编码的蛋白质,发现其功能与现代抗万古霉素物质功能相同,结构也非常相似。
这一发现并不令人意外,因为多数抗生素本来就是天然物质,是真菌或细菌杀死其他细菌的“化学武器”,不过今天在大量生产时采用人工合成而已。一些科学家猜测,在微生物“内战”中,抗药性与天然抗菌物质“道高一尺、魔高一丈”式的共同进化为时已久。
相关论文于8月31日发表在新一期《自然》杂志网络版上。新发现意味着,自然界早已有许多现成的细菌抗药基因,在抗生素带来的进化压力下,抗药菌株随时会脱颖而出,没有哪种抗生素永远有效。
第一种抗生素类药物青霉素于20世纪初被发现,40年代才广泛应用,不久人们就发现了抗药性问题。此后每一种新抗生素问世,针对它的抗药菌株都会很快出现,防止滥用和误用抗生素以遏制病菌抗药性已成为公共卫生管理的重要课题。
